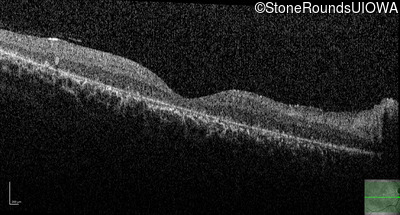
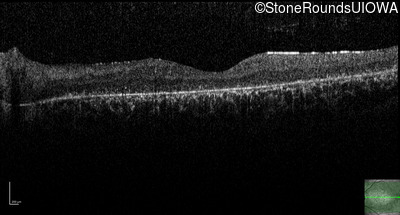
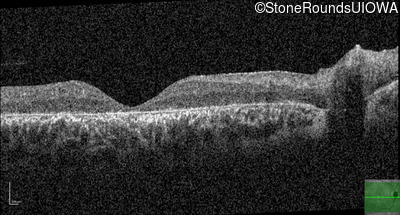
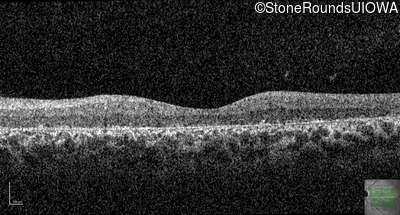

Case
SR2571
Student Mode
AR Stargardt Disease (IIA)
Male
Male
Hidden
SR2571
Student Mode
AR Stargardt Disease (IIA)
Male
Male
Highlighted Images
| Age at visit: 14 years | OD | OS |
|---|---|
History
This 14 year old male began having trouble reading before the 1st grade. His parents noticed that he would not look directly at anyone.
| Age at visit: 14 years |
| OD | OS | ||
|---|---|---|---|
| OD | OS | ||
|---|---|---|---|
| OD | OS | ||
|---|---|---|---|
| OD | OS | ||
|---|---|---|---|
| OD | OS | ||
|---|---|---|---|
| Age at visit: 16 years |
| OD | OS | ||
|---|---|---|---|
| OD | OS | ||
|---|---|---|---|
| OD | OS | ||
|---|---|---|---|
Diagnosis & molecular findings
| Disease | Gene | Allele 1 variant(s) | Allele 2 variant(s) | Inheritance mode |
|---|---|---|---|---|
| AR Stargardt Disease | ABCA4 | Ala1038Val GCC>GTC / Leu541Pro CTA>CCA | IVS36+3 del4tAAGT | AR |
Disease:
Gene:
Allele 1:
Ala1038Val GCC>GTC / Leu541Pro CTA>CCA
Allele 2:
IVS36+3 del4tAAGT
Inheritance:
AR